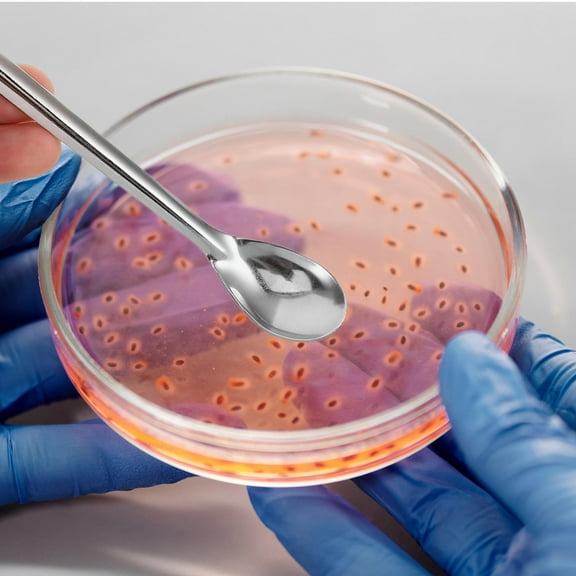
PTOOTP Stainless Steel Lab Spoon with Handle for Precise Measurement and Control

Hero image 0 of Uxcell 105mm Stainless Steel Micro Scoop Reagent Sample Spoon 2 Pack, 0 of 6
Uxcell 105mm Stainless Steel Micro Scoop Reagent Sample Spoon 2 Pack
(No ratings yet)
Current price is USD$7.00
Price when purchased online
- Free shipping
- Free 30-day returns
How do you want your item?
Columbus, 43215
Arrives between Apr 18 - Apr 23
|Sold and shipped by Tasharina Corp
4.0656488060943605 stars out of 5, based on 31244 seller reviews(4.1)
Free 30-day returns
About this item
Customer ratings & reviews
0 ratings|0 reviews
This item does not have any reviews yet